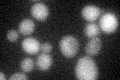
YOL133W
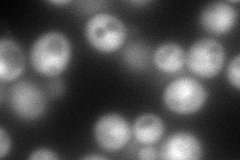
YOL133W
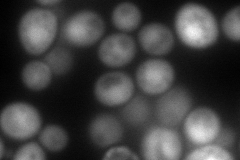
YOL133W
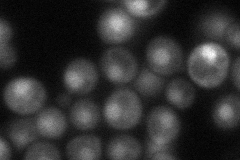
YOL133W
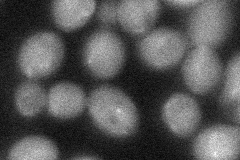
YOL133W

View description
RING finger containing subunit of Skp1-Cullin-F-box ubiquitin protein ligases (SCF); required for Gic2p, Far1p, Sic1p and Cln2p degradation; may tether Cdc34p (a ubiquitin conjugating enzyme or E2) and Cdc53p (a cullin) subunits of SCF
Localization:
Intensity:
Fold change:
Significance:
-
C’ GFP library in SD
cytosol25.25 -
N' NOP1pr-GFP in SD
cytosol,nucleus182.586 -
N' TEF2pr-mCherry in SD
nucleus181.703 -
N' NATIVEpr-GFP in SD
nucleus52.9917 -
N' TEF2pr-VC and Cyto-VN in SD
cytosol38.8991 -
C’ GFP library in SD+DTT

cytosol27.111.07No -
C’ GFP library in SD+H2O2

cytosol28.951.14No -
C’ GFP library in Starvation Media

cytosol19.520.77No -
C’ GFP library on the background of Pup2-DaMP

cytosol -
C’ GFP library on the background of CCT mutant

cytosolN/AN/ANo
